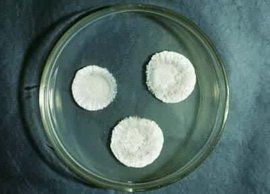
米麴黴 米麴黴

化學成分米麴黴
基本信息
Aspergillus oryzae ( Asp.oryzae)
結構介紹
米麴黴培養皿米麴黴菌落生長快,10d直徑達5~6cm,質地疏鬆,初白色、黃色,後變為褐色至淡綠褐色。背面無色。分生孢子頭放射狀,一直徑150~300μm,也有少數為疏鬆柱狀。分生孢子梗2mm左右。近頂囊處直徑可達12~25μm,壁薄,粗糙。頂囊近球形或燒瓶形,通常40~50μm。小梗一般為單層,12~15μm,偶爾有雙層,也有單、雙層小梗同時存在於一個頂囊上。分生孢子幼時洋梨形或卵圓形,老後大多變為球形或近球形,一般4.5μm,粗糙或近於光滑。
分生孢子梗長約2mm,近頂囊處直徑達12~25μm,壁薄而精糙。頂囊近球形或燒瓶形,直徑40~50μm,上復單層小梗。分生孢子幼時洋梨形或隨圓形,成熟後為球形或近球形,直徑4.5~7.0μm,表面粗糙或近於光滑。分生孢子頭直徑150~300μm。
菌落生長較快,質地疏鬆。初呈白色、黃色,後轉黃褐色至淡綠褐色,背面無色,分布甚廣,主要在糧食、發酵食品、腐敗有機物和土壤等處。是我國傳統釀造食品醬和醬油的生產菌種。也可生產澱粉酶、蛋白酶、果膠酶和曲酸等。會引起糧食等工農業產品霉變。
在生產上的作用
米麴黴是一類產複合酶的菌株,除產蛋白酶外,還可產澱粉酶、糖化酶、纖維素酶、植酸酶等。在澱粉酶的作用下,將原料中的直鏈、支鏈澱粉降解為糊精及各種低分子糖類,如麥芽糖、葡萄糖等;在蛋白酶的作用下,將不易消化的大分子蛋白質降解為蛋白腖、多肽及各種胺基酸,而且可以使輔料中粗纖維、植酸等難吸收的物質降解,提高營養價值、保健功效和消化率,廣泛套用於食品、飼料、生產曲酸、釀酒等發酵工業,並已被安全地套用了1000多年。米麴黴是理想的生產大腸桿菌不能表達的真核生物活性蛋白的載體。米麴黴基因組所包含的信息可以用來尋找最適合米麴黴發酵的條件,這將有助於提高食品釀造業的生產效率和產品質 量。米麴黴基因組的破譯,也為研究由麴黴屬真菌引起的麴黴病提供了線索。
米麴黴的培養
固態培養方法( solid state cultivation ) :主要有散曲法和塊曲法。部分黃酒用曲,紅酒及醬油米麴黴培養屬散曲法,而黃酒用曲及白酒用曲一般採用塊曲法。
固態制曲設備:實驗室主要採用三角瓶或茄子瓶培養;種子擴大培養可將蒸熱的物料置於竹匾中,接種後在溫度和濕度都有控制的培養室進行培養;工業上目前主要是厚層通風池制曲;轉式圓盤式固態培養裝置正在試驗推廣之中。
固態培養微生物,主要用於黴菌的培養,但細菌和酵母也可採用此法。其主要優點是節能,無廢水污染。單位體積的生產效率教高。
實驗過程:
米麴黴菌種的純化,製成斜面,將斜面菌種接入 250ml 三角瓶培養成種曲,再將種曲擴大培養 ( 500ml )三角瓶。
米麴黴培養:
分為斜面培養和三角瓶培養兩個階段。三角瓶培養物在工廠中作為一級種子。試管斜面培養基:豆餅浸出汁: 100 克豆餅,加水 500ml ,浸泡 4 小時,煮沸 3-4 小時,紗布自然過濾,取液,調整至 5 波美度。每 100ml 豆汁加入可溶性澱粉 2 克,磷酸二氫鉀 0.1 克,硫酸鎂 0.05 克,硫酸銨 0.05 克,瓊脂 2 克,自然 pH 。或採用馬鈴薯培養基:馬鈴薯 200 克,葡萄糖 20 克 ,瓊脂 15-20 克,加水至 1000ml ,自然 pH 。
三角瓶培養基製備:
米麴黴的培養基 :
1 :麩皮 40 克,麵粉(或小麥) 10 克,水 40ml 。
2 :豆粕粉 40 克,麩皮 36 克,水 44ml 。
裝料厚度 : 1cm 左右;
滅菌: 120 ℃,30min;
接種及米麴黴的培養條件: 米麴黴固態培養主要控制條件:溫度,濕度,裝料量,基質水分含量。固態培養前,原料的蒸熟及滅菌是同時進行的,實驗室一般是在高壓滅菌鍋中進行;但在工廠中則是原料的煮熟和滅菌與發酵分別在不同的設備中進行。這點與液態發酵是不同的。 28-30℃,培養20小時後,菌絲應布滿培養基,第一次搖瓶,使培養基鬆散;每隔8小時檢查一次,並搖瓶。培養時間一般為72小時。
3. 實驗儀器、設備和材料
恆溫培養箱或者固態培養室,負壓式超淨工作檯,顯微鏡,水浴鍋,試管,茄子瓶,平板和 500ml 三角瓶等。
動畫中的米麴黴
在2007年10月上映的日本11話TV動畫《萌菌物語》(又名:《豆芽小文》),米麴黴因其可愛形象與爆笑劇情成為了年輕人的新寵!
動畫《萌菌物語》中的米麴黴動畫《萌菌物語》講述了
一個用肉眼可以看見細菌世界的主人公小文在東京農業大學裡的日常生活。而米麴黴則是眾多細菌(真菌)中戲份最多的一種。
動漫界當中體積最小的動漫角色。這位以擬人化口吻說著各種可愛台詞,又以無限美化後的超萌外表來博得觀眾歡心的動漫角色,在現實中體積細小到肉眼無法察覺,其頂囊通常只有40~50μm(微米)大小,比起一切正太蘿莉都要渺小得多
米麴黴菌物界(三)
| “菌物界”這個名詞是我國學者裘維蕃等於1990年提出的,並已得學術界的一定支持,這是指與動物界,植物界相併列的一大群無葉綠素,依靠細胞表面吸收有機養料,細胞壁一般還有幾丁質的真核微生物。一般包括真菌,粘菌和假菌(卵菌等)3類。 |